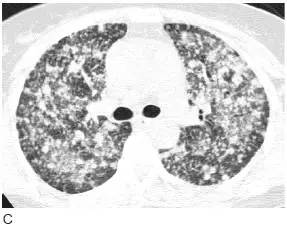

转:5类肺癌的影像学表现(多图)
1、鳞状细胞癌
影像学表现常见息肉状腔内肿块和( 或) 支气管阻塞( 图1A)。肺门的肿块也很常见,这归因于肿瘤位于中心位置,可侵犯局部组织,累及肺门淋巴结( 图1B)。肺不张( 图2)、实变、黏液嵌塞和支气管扩张常见, 提示支气管阻塞。只有30%的鳞癌表现为肺外围结节。中央坏死和空洞( 图3) 较其他类型肺癌更常见。

图1 表现为支气管管腔内和肺门肿块的鳞状细胞癌
A.CT 显示右下叶支气管内息肉状的肿块( 箭头),为典型的鳞状细胞癌;
B. 在稍低层面,支气管腔阻塞伴局部浸润,导致肺门肿块(M)

图2 鳞状细胞癌伴支气管阻塞和肺不张
胸片显示右肺门大肿块(M) 伴水平裂向上弯曲移位( 小箭头)。呈反“S”征,可见纵隔淋巴结增大( 大箭头)


图3 鳞状细胞癌伴空洞
A. 胸片显示右上叶大的厚壁空洞;
B.CT 显示厚壁空洞及壁结节,为恶性空洞的典型征象,属T2 期
2、腺癌
在胸片上腺癌因其边缘不规则常表现为边缘显示不清( 图4A)。在高分辨率CT 上, 腺癌表现为圆形或分叶状的孤立结节。由于邻近肺浸润,其边缘常不规则呈毛刺边缘( 图4B)。当发生在胸膜下时,可表现为细线状延伸至胸膜面( 即胸膜尾)( 图4C)。CT 可显示结节内空气支气管征。虽然中央坏死很常见,但在平片或CT 上空洞并不常见。当腺癌起源于中央支气管壁时,影像学很难与鳞癌相鉴别。


图4 腺癌的典型表现
A. 腺癌患者胸片显示左肺尖边界不清的结节( 箭头), 在胸片上因病灶边界不规则和边缘毛刺,腺癌常表现边界模糊结节;
B. 左上叶腺癌患者高分辨率CT 显示左上叶孤立结节,边缘不规则伴毛刺。毛刺是由于肿瘤伴肺纤维所致。肿瘤分期为T1;
C. 腺癌患者高分辨率CT 上显示右上叶后段的孤立结节呈分叶状,边缘可见毛刺, 结节延伸至胸膜的表面( 箭头) 称胸膜尾征,由纤维束牵拉脏层胸膜表面而形成
3、细支气管肺泡癌(BAC)
由于其匍匐生长模式,平片和CT 表现为边缘模糊的结节(图5)。在HRCT 上,局灶性的BAC 表现为磨玻璃样结节,有时伴有部分软组织密度致密影(图6),常含空气支气管征或空泡征。空泡征指肿瘤内囊状充气区,称为“假空洞”(图5B)。


图5 局灶性细支气管肺泡癌(BAC)
A. 胸片显示了左肺边界很模糊的结节( 箭头);B.5mm 层厚的CT 显示了边界不清、不规则、毛刺状的结节,含空气支气管征和空泡征,为BAC 的典型征象

图6 局灶性细支气管肺泡癌
A.5mm 层厚的CT 显示边界不清的结节;B.HRCT 显示结节大部分呈磨玻璃样,为匍匐生长肿瘤的典型征象
在40%的病例中,BAC 呈弥漫性或多灶性肺浸润,表现为肺实变或多发的模糊结节( 图7,图8,图9)。这种表现尤其见于BAC 的黏液亚型。尚不清楚这种表现是由肿瘤的多中心起源还是肿瘤支气管内的播散所导致。
这类肿瘤也可见匍匐生长,肿瘤细胞沿肺泡壁排列,产生黏液充填肺泡腔,导致了影像上的实变表现。常见CT 血管造影征,即在实变的肺里可见CT 增强后呈高密度血管影。弥漫性BAC 患者会产生大量的水样痰,称为支气管黏液溢,是大量黏液产生的结果。弥漫性BAC 预后不良。

图7 弥漫性细支气管肺泡癌
A. 胸片显示右肺基底部的实变( 箭头);
B.5mm 层厚的CT 显示多个区域的实变,含有空气支气管征,多发的边界不清的结节,这些结节呈小叶中央分布,代表气腔或腺泡结节,在弥漫性细支气管肺泡癌中很常见

图8 弥漫性细支气管肺泡癌侵犯两上叶,伴实变和空气支气管征

图9 弥漫性细支气管肺泡癌(BAC)
A. 伴双肺实变的BAC;
B. 伴两肺模糊小结节;
C. 同一患者高分辨率CT 显示弥漫分布的小结节
4、小细胞肺癌肺
小细胞肺癌常发生在主支气管或叶支气管,造成广泛的支气管周围侵犯,形成肺门增大或肺门旁肿块( 图10)。支气管腔内肿块较鳞癌少见,但大的肿块常压迫支气管( 图11) 引起肺不张。这种肿瘤常伴有显著的纵隔淋巴结增大( 图12),是引起上腔静脉阻塞综合征的常见原因。少于5%的病例表现为肺结节。


图10 小细胞肺癌
A. 胸片显示右肺门大肿块( 箭头);
B.CT 显示大肿块(M),中叶小叶间隔增厚引起的间质增厚提示肿瘤沿淋巴管播散

图11 小细胞肺癌
对比增强CT 显示肺门巨大肿块(M),肿瘤包绕并使中间段支气管狭窄( 大箭头),并延伸至隆突下间隙内,局部浸润引起心包增厚( 小箭头),左侧可见胸腔积液

图12 小细胞肺癌
对比增强CT 显示典型的小细胞肺癌广泛纵隔淋巴结增大,气管前淋巴结增大致上腔静脉( 箭头) 向前移位并明显狭窄,可见前纵隔淋巴结融合的大肿块,右侧可见胸腔积液
5、大细胞肺癌
常表现为大的周围型肿块,超过60%的病例肿块大于4cm( 图13)。其影像学特征( 除肿块较大外)、组织学超微结构、存活率与腺癌相似。


图13 大细胞肺癌
A. 胸片显示左肺巨大肿块;B. 在对比增强CT 上,巨大肿块占据左肺,左侧胸腔可见积液
收藏
回复(4)参与评论
评论列表
























